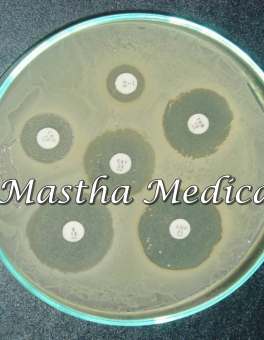

● online
- Mesin Spin Deposit Live Kasino 2025....
- Mifinity Casino No Deposit Bonus....
- Slot Online Deposit Murah....
- Situs Terbaik Kasino Gratis Tanpa Uang....
- Kasino Org Casino No Deposit Bonus....
- Jual Manset Tensimeter Dewasa Adult Perekat 2 Sela....
- Situs Judi Slot Online Bonus Klien Baru....
- Apk Slot Online Uang Asli Tanpa Deposit....
New Lab Instrument Disintegration testing Tablet Disintegration tester
Rp 25.000.000 Rp 30.000.000| Stok | Tersedia (10) |
| Kategori | Alat Laboratorium |
New Lab Instrument Disintegration testing Tablet Disintegration tester


New Lab Instrument Disintegration testing Tablet Disintegration tester BJ-2
Applicable standard
National standard (Chinese Codex) /2000/
Corporate standard (Disintegration tester) Q/12xQ0188-2004
Introductions:
BJ series of instruments are used for detecting disintegration of solid in prescriptive conditions
Features
1.Auto stop at timing point. Each test station is driven independently.
2.There are six tubes in basket assembly.
3.The bath liquid can achieve an even temperature.
4.Automation: auto-test, Auto-diagnose, auto-alarm.
5.Timing at will. The preset and real time data can be displayed alternately time.
6.A MPU is used to automatically control the temperature, time and frequency of nacelle
Back and forth.
Specifications
Basket assembly 2
Niacelle back and forth frequency 30-32 min
Niacelle back and forth range 54-56 min
Automation time range 5-120 min
Accuracy of controlling temperature 37 +- 0.5 degree
Power 500w
Dimension 400x300x420 mm
Weight 16kg
New Lab Instrument Disintegration testing Tablet Disintegration tester
| Berat | 16000 gram |
| Kondisi | Baru |
| Dilihat | 686 kali |
| Diskusi | Belum ada komentar |
Box Blue Tips OneLab Onemed adalah tempat atau wadah plastik untuk blue tips (micropipet tips ukuran besar) isi 100 lubang. Spesifikasi : – Nama : Box Blue tips Onelab – Ukuran: 127x103x97 mm – Merek : Onemed – Satuan: pcs – KEMENKES RI AKD 20805510328 NB : PENGIRIMAN HANYA DAPAT KAMI LAKUKAN MELALUI… selengkapnya
Rp 100.000 Rp 150.000El Blue tip adalah alat laboratorium kesehatan yang digunakan dalam penelitian yang mempunyai fungsi untuk mengambil larutan dalam ukuran mikro (100 ul sampai 1000 ul), Blue Tip di buat dari bahan yang berkualitas yang kuat dan persisi. Cocok digunakan di rumah sakit, klinik, Laboratorium rumah sakit, dan universitas. Spesifikasi : – Nama : Blue… selengkapnya
Rp 97.000 Rp 110.000El Kertas golongan darah Kertas golongan darah yaitu penggunaan kertas bioaktif yang dapat langsung memberikan informasi golongan darah seseorang. Spesifikasi : – Nama barang : Kertas golongan darah – Isi : 100 pcs Kami senang jika bisa melayani Anda 🙂
Rp 75.000 Rp 100.000Rk CENTRIFUGE merupakan alat laboratorium yang memanfaatkan gaya sentrifugal , yaitu gaya yang timbul akibat benda yang diputar dari satu titik sebagai porosnya . untuk memisahkan partikel dari satu benda cair atau dengan kata lain memisahkan benda cair dari kepadatan yang berbeda . benda cair ini merupakan cairan tubuh , contoh darah , serum ,… selengkapnya
Rp 2.450.000 Rp 2.650.000NB : UNTUK PENGIRIMAN WAJIB MENGGUNAKAN EKSPEDISI JNE YES Ik Media Tumbuh Mueller Hinston Agar Disposable Alat laboratorium 1 Pack Mueller Hinston Agar adalah media pertumbuhan mikrobiologis atau bakteri yang terbuat dari bahan plastik yang biasanya digunakan untuk pengujian kerentanan antibiotik. Spesifikasi : – Nama : mueller hinston agar – isi 1 pack :… selengkapnya
Rp 800.000 Rp 1.050.000pt Disposable syringe merupakan alat bantu medis yang berupa pompa piston sederhana untuk menyuntikkan atau menghisap cairan atau gas. Merk : Stera Bahan : Plastik… selengkapnya
Rp 125.000Ts Kit Lengan Pelatihan Multi-Vena Pediatrik IV Reproduksi lengan pediatrik seperti aslinya dengan kulit yang dapat diganti dan sistem multi-vena yang dirancang untuk terapi intravena perifer. Firtur : ➜ Venipuncture mungkin di fossa antecubital dan dorsum tangan ➜ Vena yang dapat diakses termasuk median, basilic dan cephalic ➜ Arm akan mengartikulasikan manikin pediatrik dan pelatih… selengkapnya
Rp 25.000.000 Rp 30.000.000dn Urine Container 100 ml Non sterile Specimen Container 1 Pack Isi 200 Urine Container adalah tempat sample urine dari bahan plastik bertutup ulir berukuran 100 ml, selain untuk kesehatan bisa juga untuk tempat benda lainnya sesuai dengan kebutuhan . Tabung non label. Cocok digunakan di Laboratorium . Spesifikasi : -Nama : Urine Container 100… selengkapnya
Rp 1.215.000 Rp 1.450.000Box white tips adalah tempat atau wadah yang digunakan untuk white tips ( micropipet tips ukuran kecil) isi 96 Spesifikasi : – Nama : Box white tips -Warna : Putih – Merek : Onemed – Ukuran: 112x78x63mm – Satuan : pcs – KEMENKES RI AKD 20805510328 Kami senang jika bisa melayani Anda 🙂
Rp 70.000 Rp 86.000Rk Pipet Drop Plastik / Pipet Tetes Obat / Pipet kosmetik / Pipet Susu Pipet Drop terbuat dari plastik dan penyedot dari karet yang dapat dgunakan untuk anak meminum obat atau mengukur cairan tetes lainnya sebagai Pipet Kosmetik / Pipet Susu. Spesifikasi : Nama : Pipet Drop / Pippete Dropper Skala : 0.1 – 1.0… selengkapnya
Rp 50.000 Rp 85.000

Belum ada komentar, buka diskusi dengan komentar Anda.